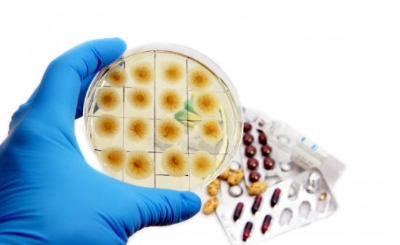

티스토리 뷰
실수는 어떠한 일을 망치는 원인이 되기도 하지만 때로는 풀리지 않는 난제를 풀게 하거나, 생각지 못한 것을 떠오르게 하는 영감을 줄 때가 있는데요. 실생활에서 편리하게 사용하는 여러 도구와 생활필수품 역시 이러한 실수로 생기는 경우가 있다고 합니다. 그래서 오늘은 우연한 실수로 만들어진 여러 발명품에 대해 알아보도록 하겠습니다.
실수로 만들어진 발명품

1. 포스트잇
실수로 만들어진 첫 번째 발명품은 포스트잇입니다. 1970년에 3M사에서는 강력한 접착제를 만들기 위해 지속적인 연구를 하고 있었는데요. 연구원으로 재직 중이던 스펜서 실버는 강력 접착제를 개발하던 중 실수로 접착력이 약하고 끈적임이 없는 접착제를 만들게 되었는데요. 접착제의 본래 기능이 한 번 붙으면 잘 떨어지지 않는 것이기에 스펜서 실버의 개발품은 실용성이 없다고 실패작이라고 여겼다고 합니다. 그 이후 같은 연구소 직원인 아서 프라이가 교회의 성가대원 활동 중에 실버의 접착제를 사용하게 되었고, 뛰어난 가능성을 직감한 이후 개량을 거친 이후에 포스트잇을 개발했다고 합니다. 이후 서서히 대중화가 되면서 최고의 사랑을 받는 사무용품으로 거듭나게 되었습니다.
2. 페니실린
세계 최초로 상용화된 항생물질인 페니실린 역시 실수로 탄생한 대표적인 발명품으로 알려져 있습니다. 영국의 미생물학자인 플레밍은 부스럼의 원인인 포도상구균을 배양하고 있던 중 실수로 전날 배양한 세균을 현미경으로 관찰한 뒤 배양기의 뚜껑을 닫지 않았다고 합니다. 그 이후 우연히 뚜껑을 닫지 않은 배양기에 푸른곰팡이 포자가 날아와 붙었고, 곰팡이가 핀 배양기의 세균이 모두 죽어있는 것을 발견하게 됩니다. 플레밍은 푸른곰팡이가 폐렴균과 탄저균 등의 세균을 죽인다는 사실을 알아내고는 '가는 털이 많다'라는 뜻으로 페니실린이란 이름을 붙였습니다. 이러한 페니실린은 포도상구균 이외에도 여러 종류의 치명적인 병원균을 없애는데 뛰어나 세계를 바꾼 발명품 중 하나로 손꼽히고 있습니다.

3. 전자레인지
전자기파를 이용하여 냉동된 식재료들을 해동시키는 역할 뿐만 아니라 다양한 요리를 할 수 있는 생활가전인 전자레인지도 실수로 우연히 만들어진 발명품이라고 합니다. 미국의 방위 사업체인 레이시온의 엔지니어였던 퍼시 스펜서는 마그네트론에 대한 실험을 하고 있었는데요. 마그네트론이 작동 중이던 실험실에 들어간 이후 간식으로 먹으려고 준비한 초콜릿바가 녹아있는 것을 발견하게 됩니다. 이런 우연한 일에 흥미를 느낀 퍼시 스펜서는 초콜릿이 녹은 것과 마이크로파의 연관성에 지속적인 연구를 하게 되고, 이후 여러 연구와 실험을 통해 전자레인지를 발명하게 됩니다.

4. 가황고무
타이어를 비롯한 구명보트, 장갑, 튜브, 벨트 및 각종 부속품에 널리 사용되는 가황고무 역시 실수로 우연히 만들어진 발명품이라고 합니다. 고무나무의 수액을 모아서 만드는 천연고무는 오래전부터 있었지만 냄새가 심하고, 온도가 높으면 녹아버리는 성질 때문에 실생활에서 사용하기 어려웠다고 합니다. 1839년 미국의 발명가였던 찰스 굿이어는 고무에 관련된 실험을 계속하고 있었다고 하는데요. 연구를 계속 하던 어느 날 고무에 황을 섞어 실험하다가 실수로 고무 덩어리를 난로 위에 떨어뜨렸는데, 고무가 녹지 않고 약간 그을리기만 하는 것을 보게 됩니다. 이러한 것에 힌트를 얻어서 고무에 황을 섞어 적당한 온도와 시간으로 가열하게 되면 고무의 성능을 크게 높일 수 있다는 사실을 알게 되는데요. 이후 계속된 연구 끝에 가황법이라는 고무 가공법을 확립하여 고무 공법의 획기적인 발전을 이루게 됩니다.

5. 벨크로
실수로 우연히 만들어진 발명품 중에는 찍찍이라고도 잘 알려진 벨크로도 있는데요. 1941년 스위스의 엔지니어였던 조르주 드 메스트랄은 강아지와 함께 산책을 하면서 바지와 강아지의 털에 도꼬마리 가시가 붙은 것을 발견하게 됩니다. 그 모습을 눈여겨 본 그는 도꼬마리를 가시를 모방한 작은 돌기를 이용한 잠금장치 아이디어를 떠올리고 벨크로를 발명하게 됩니다. 벨크로는 프랑스어로 벨벳을 뜻하는 블루아(velours)와 걸쇠나 걸이를 뜻하는 크로셰(crochet)를 결합한 단어라고 합니다.

6. 잉크젯 프린터
잉크를 가늘게 분사하여 인쇄하는 프린터인 잉크젯 프린터는 캐논사의 연구원이었던 엔도 이치로의 우연한 실수로 탄생한 발명품이라고 합니다. 엔도 이치로는 어느 날 꽉 찬 잉크통이 우연히 뜨거운 땜질 인두에 닿는 것을 보게 되는데요. 인두의 열은 잉크의 양을 팽창시켜 잉크가 뿜어져 나오게 만들고, 이것을 본 엔도 이치로는 잉크 분출을 제어할 수 있는 해결책이란 것을 깨달았으며 수 일 내 작동 가동한 모델을 만들게 되었다고 합니다. 이러한 모델이 개량 과정을 거친 이후 잉크젯 프린터가 개발되어 판매되면서 전 세계적인 인기를 끌게 되었습니다.
이상 실수로 만들어진 발명품에 대해 알아보았습니다. 소개된 여러 정보들이 많은 도움이 되길 바라며 오늘 하루도 행복하고 건강한 하루 되시길 바랍니다.
'상식' 카테고리의 다른 글
| 블랙프라이데이 뜻과 유래에 대해 살펴봐요 (0) | 2022.10.27 |
|---|---|
| 비엔나커피 유래 정보 확인해볼게요 (0) | 2022.08.01 |
| 실수로 만들어진 음식 살펴볼게요 (0) | 2022.06.14 |
| 프라이드치킨 유래 및 기원 알아보아요 (0) | 2022.06.09 |
| 마카롱 유래 정보에 대해 알아보아요 (0) | 2022.05.28 |